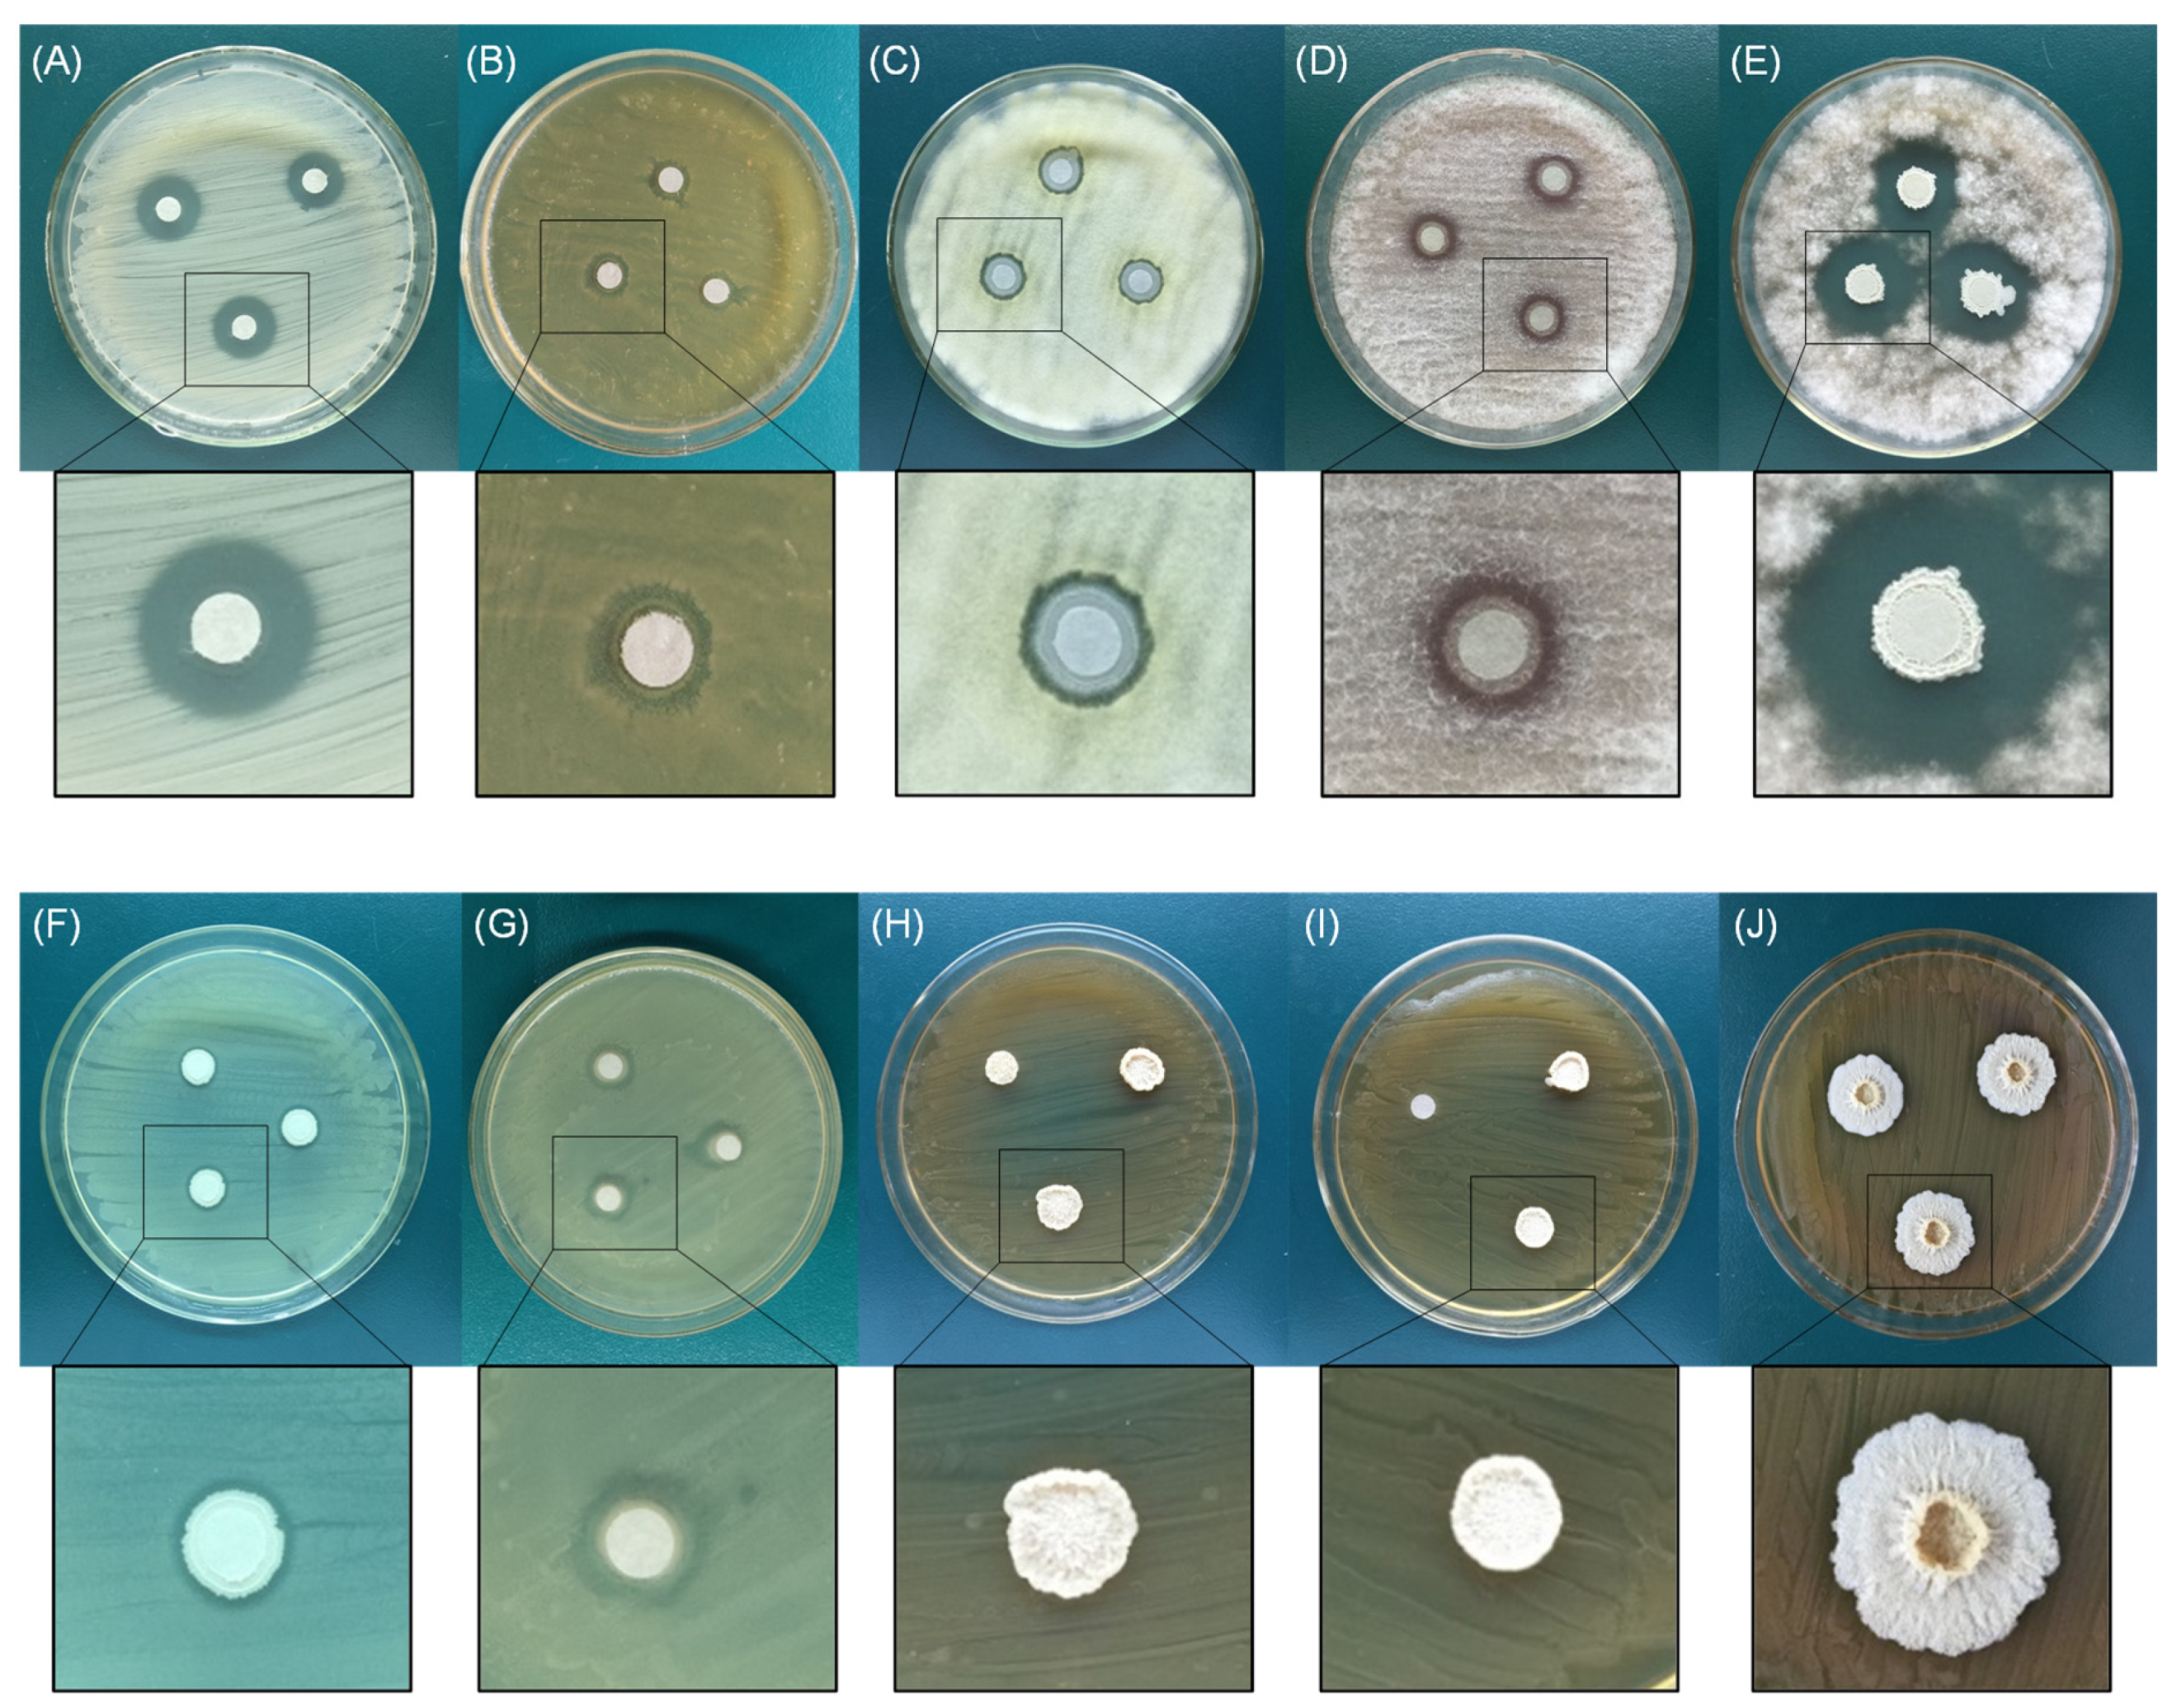
Agriculture 14 00830 g003

1. Introduction
Silage is a type of moist, stored, and nutrient-rich feed formed by fermenting fresh greenfeed with lactic acid bacteria (LAB) under anaerobic conditions [
1]. It breaks the seasonal limitations and is an important guarantee for ruminant overwintering feed [
2]. During the ensiling process, LAB (such as
Lactobacillus plantarum,
Lactobacillus casei,
Lactobacillus reuteri, etc.) produces a large amount of lactic and acetic acids to form an acidic environment. This phenomenon quickly reduces the pH of the silage system to around 4.0, inhibits the activities of undesirable microbes [
3], and produces antagonistic metabolites, such as nisin, ε-polylysine, and phenyllactic acid, which inhibit the growth of pathogenic and rot-causing microorganisms [
4] and improve the nutritional properties and safety of silage [
5]. To some extent, the ensiling of forage grass alleviates the problem of a lack of high-quality forage materials in winter in some farming areas in China. However, during actual production and application, silage faces the risk of pollution and deterioration because forage itself carries impurities, such as rot-causing microorganisms (such as
Aspergillus niger,
Fusarium oxysporum,
Fusarium graminearum, etc.), soil, and uncompacted raw materials. After the silo has been opened, the silage comes into contact with oxygen. This results in the recovery and rapid multiplication of rot-causing microorganisms, increased silage pH, reduced aerobic stability and quality, nutrient loss, decreased animal feed utilization, and the production of multiple mycotoxins [
6,
7], thus compromising the animals’ health.
In addition to the large number of LAB, aerobic microorganisms (such as yeasts, coliforms, and molds) are present in silage and seriously affect its stability during aerobic exposure [
8,
9]. Responsible for the spoilage of silage are
Fusarium,
Aspergillus niger,
Aspergillus flavus, and
Penicillium [
10,
11]. It is common to add citric, fumaric, and formic acids and other acidity regulators into silage feed as preservatives to inhibit the proliferation of these spoilage microorganisms and reduce losses [
12,
13]. However, this process requires repeated spraying, is costly, and negatively affects the palatability of feed. Whole-plant corn silage has become the predominant forage used in dairy cattle diets worldwide [
14]. The spoilage of corn silage caused by pathogenic and rot-causing microorganisms can affect the individual herd as well as impact the overall profitability of the industry [
15].
Based on this, we hypothesize the existence of microorganisms in silage that can inhibit the growth of pathogenic and spoilage microorganisms without affecting the growth of some LAB. The aim of this study is to screen the microorganism and investigate its impact on fermentation quality, aerobic stability, and in vitro ruminal methane production.
2. Materials and Methods
2.1. Materials
Samples: Rotten silage (whole-plant corn silage) was collected from Huangshan Junfeng ecological cattle farm (Huangshan, China). Whole-plant corn (Qingzhu No. 6) was grown in an experimental field at Anhui Agricultural University (latitude: 31°58′ N, 117°24′ E). Culture media: nutrient, Luria-Bertani (LB), and deMan, Rogosa, and Sharpe (MRS) broths, and potato dextrose agar (PDA) (HB0108, HB0128, HB0384-1, and HB0233; Qingdao Hi-Tech Industrial Park Hope Bio-Technology Co., Ltd., Qingdao, China). About 20 g/L of agar powder (HB8274, Qingdao Hi-Tech Industrial Park Hope Bio-Technology Co., Ltd., Qingdao, China) was added to each broth to prepare solid culture media. Indicator microorganisms: Escherichia coli (E. coli), Staphylococcus aureus (S. aureus), and Salmonella enteritidis (S. enteritidis) were used as pathogenic indicator microorganisms. Aspergillus niger (A. niger), Saccharomyces cerevisiae (S. cerevisiae), Fusarium oxysporum (F. oxysporum), and Fusarium graminearum (F. graminearum) were used as rot-causing indicator microorganisms. Lactobacillus casei (L. casei), Lactobacillus reuteri (L. reuteri), and Enterococcus faecium (E. faecium) were used as LAB (probiotic) indicator microorganisms. E. coli, S. aureus, S. enteritidis, L. casei, L. reuteri, and E. faecium were obtained from the Anhui Province Engineering Laboratory for Animal Food Quality and Bio-safety (Hefei, China); A. niger, S. cerevisiae, F. oxysporum, and F. graminearum were obtained from the Anhui Academy of Agricultural Sciences (Hefei, China).
2.2. Isolation Procedure
- (1)
Primary screening: Plant tissues with intact structure and no fungal colonies from rotten silage were collected as test samples. The samples were immersed in sterilized physiological saline (sample/physiological saline = 1 g: 9 mL), vortexed for 5 min, and incubated at 28 °C for 24 h. An asepsis mop was used to collect the sample solution, which was spread onto nutrient agar (NA) and cultured at 37 °C with an O2 concentration ≤ 0.5% for five days. After the microorganisms had grown, the strains with different colony morphologies were picked up separately and subjected to isolation and purification, and the purified strains were inoculated into nutrient broth and incubated statically at 37 °C for 24 h.
- (2)
Second screening: To assess the bacteriostatic properties of purified strains using the Kirby–Bauer (K-B) method, a disk diffusion test was performed on the tested bacteria [
16]. The fermentation fluid of the tested bacteria, LABs, pathogenic microorganisms, and yeasts in a stationary phase was collected separately, and the concentration of each microbe was adjusted with phosphate buffered saline (PBS) to ×10
6 CFU/mL. The culture mediums inoculated with rot-causing molds were taken, the spores were rinsed with sterile normal saline containing 0.05% Polysorbate-80, and the mycelia were scraped to prepare a spore suspension or mycelium suspension. Then, the indicator microorganism suspensions were spread using sterilized swabs from the plates. The pathogenic microorganisms were inoculated on an LB medium, the rot-causing microorganisms were inoculated on a PDA medium, and the LAB were inoculated on an MRS medium. After allowing the surface of each medium to dry for 3–5 min, dry sterile ADVANTEC paper (Toyo Roshi Kaisha, Ltd., Tokyo, Japan) disks (Φ = 6 mm, δ = 0.7 mm) were placed on the plates and pressed with forceps to ensure complete contact with each agar surface. A total of 10 μL of the tested bacteria solution (×10
6 CFU/mL) was loaded onto the paper disks on the agar plates, spread, and cultivated for 24 h–72 h at 37 °C (bacteria) or 28 °C (fungi) to observe and measure the inhibition zones. All the experiments were conducted 3 times. The microorganisms that could inhibit the growth of pathogenic and rot-causing microorganisms were screened but had no effect on LAB growth.
2.3. Identification
- (1)
Morphological tests: after Gram staining, the morphological characteristics of a single colony after purification were observed using oil immersion microscopy.
- (2)
Physiological and biochemical tests: the tests were conducted in accordance with Bergey’s Manual of Determinative Bacteriology [
17].
- (3)
Genetic tests: The genomic DNA from stable culture fluid was extracted using a Bacteria Genomic DNA Kit (Trelief
®, Tsingke Biotechnology Co., Ltd., Beijing, China), and its 16S rDNA gene fragment was amplified using two universal bacterial primers (namely, 27F: 5′-AGAGTTTGATCCTGGCTCAG-3′ as the forward primer and 1492R: 5′-GGTTACCTTGTTACGACTT-3′ as the reverse primer). Totals of 27 μL PCR mix (GoldenStar
® T6 Super PCR Mix Ver.2, Tsingke Biotechnology Co., Ltd., Beijing, China), 1 μL forward primer, 1 μL reverse primer, and 1 μL DNA template were used for the PCR reaction. The PCR reaction conditions are as follows: initial denaturation at 98 °C for 180 s, followed by 35 cycles of denaturation at 98 °C for 10 s, annealing at 55 °C for 10 s, and extension at 72 °C for 10 s. The final extension was made at 72 °C for 120 s. The PCR products were sent to Nanjing Tsingke Biotechnology Co., Ltd. (Nanjing, China) for sequencing. The 16S rDNA sequence obtained was explored using BLAST (
https://blast.ncbi.nlm.nih.gov/Blast.cgi) (accessed on 28 June 2022) to query for highly similar sequences, and the relative phylogenetic position of the isolate was determined using ML tree analysis with MEGA7.0 ver.
2.4. Growth Characteristics
About 2 mL of bacterial solution (OD
600 = 0.6) was inoculated into 100 mL of nutrient broth and cultivated at 140 rpm and 37 °C. The OD at 600 nm wavelength was measured every 2 h, and a growth curve was drawn [
18]. The fermentation fluid in the stationary phase was inoculated into the nutrient broth to obtain a 1% concentration and cultured at different temperatures (30, 40, 50, 60, and 70 °C) and pH values (2, 4, 6, 8, and 10) for 12 h. Viable counts were determined. The measurements were repeated three times.
2.5. Lactic Acid Tolerance
The pH conditions of silage were simulated. The pH of the nutrient broth was adjusted to 4 by using lactic acid [
3], and the nutrient broth was filtered through a Millipore filter (0.2 μm). The tested bacterial solution (×10
6 CFU/mL) was inoculated into the nutrient broth at 2% inoculum volume and cultured at 37 °C. The samples were collected at 0, 12, 24, 36, and 48 h for viable bacterial counting. The experiment was repeated three times.
2.6. Antibiotic Resistance
The minimum inhibitory concentration (MIC) of 8 antibiotics for
Bacillus spp., regulated by the European Food Safety Agency (EFSA) [
19] against D-2 (tested bacteria), was tested with the broth microdilution method according to the guidelines of the Clinical and Laboratory Standards Institute (CLSI) [
20]. The concentration (mg/L) range of 8 antibiotics (Shanghai Yuanye Bio-Technology Co., Ltd., Shanghai, China) used in the test is as follows [
21]: Vancomycin (0.25–16.00); Gentamicin (0.25–32.00); Erythromycin (0.25–16.00); Clindamycin (0.25–8.00); Tetracycline (0.5–32.00); Chloramphenicol (1.00–64.00); Kanamycin (1.00–64.00); Streptomycin (0.25–32.00). The MIC values were determined after being placed at 35 °C and incubated for 20 h, and the results were judged against antibiotic susceptibility standards based on the live bacterial components used as feed additives as specified by EFSA.
2.7. Silage Preparation and Oxygen Exposure
Whole-plant corn (dough stage) was chopped into approximately 1–2 cm segments and then left to wilt via air drying at an ambient temperature to a DM concentration of 31.40% fresh weight (FW). The chopped forage was randomly divided into 10 sub-samples (2 treatments × 5 replicates, about 500 g for each sub-sample) and then randomly assigned to one of the following treatments: (1) D-2, the dosage of inoculation was 1 × 106 CFU/g fresh forage, which was mixed thoroughly in a disinfected plastic container; (2) Control group, in which an equal volume of distilled water was applied under the same conditions. The treated or untreated forages were packed into polyethylene plastic bags (290 mm × 230 mm; fermented feed bag with a one-way valve; Wenzhou Wangting Packaging Co., Ltd., Wenzhou, China) and ensiled individually, vacuum-sealed, and stored in an air-conditioned room (25 ± 2 °C) for 60 d.
The silage samples in the D-2 and control groups at 60 days after fermentation were held separately in a sterile beaker (200 g each), covered with plastic film, incubated at 28 °C and 75% RH, exposed to air at intervals of 12 h, and then thoroughly stirred for 5 min per day with a sterile glass rod; this operation was repeated for 10 d. The samples were collected 60 days after fermentation and 10 days after aerobic exposure for the analysis of fermentation quality, microbial population, and chemical composition.
2.8. Analysis of Aerobic Stability, Chemical Composition, and In Vitro Gas Production of Silage
Each group of silage was evaluated in accordance with the scoring method of the Deutsche Landwirtschafts-Gesellschaft [
22]. The samples (10 g) from each group were diluted in 90 mL of sterilized physiological saline, and the mixture was thoroughly mixed. A portion (50 mL) was further diluted to 10
−2 with sterilized physiological saline, and 100 µL diluted samples were spread onto MRS or Rose Bengal agar to determine the total LAB, yeast, and mold counts [
23]. The MRS plates were incubated anaerobically for 72 h at 37 °C, and the Rose Bengal plates were incubated aerobically at 28 °C for 48 h. The pH of another silage extract aliquot was measured using a KASVI potentiometer [
24]. The organic acid and water-soluble carbohydrate (WSC) contents were measured using high-performance liquid chromatography methods [
25].
The Kjeldahl method [
26] was used to determine the total nitrogen (TN) content, and the phenol-sodium hypochlorite method [
27] was used to determine the ammoniacal nitrogen (NH
4+-N) concentration of silage. The neutral detergent fiber (NDF) and acid detergent fiber (ADF) contents of the silage were presented based on their dry matter (DM) bases. The determination methods of DM, NDF, and ADF contents were referenced according to Bai et al. [
28] and Van Soest et al. [
29].
The ruminal fermentation of whole-plant corn silage samples was conducted using an in vitro gas production technique; the in vitro dry matter digestibility (IVDMD) and methane production of silage were determined using the method of Khota et al. [
30].
2.9. Statistical Analysis
Data on growth characteristics (temperature and pH), bacteriostatic spectrum, and survival rate of D-2 were analyzed using a one-way ANOVA on SPSS 17.0 (SPSS, Inc., Chicago, IL, USA), and data on fermentation quality, aerobic stability, digestion, and methane production of whole-plant corn silage were analyzed using unpaired t-tests. All the values are expressed as mean ± SD, and the minimum and maximum levels of significance were set to p < 0.05 and p < 0.01, respectively. Origin7.5 (OriginLab, Northampton, MA, USA) was used to draw the figures.
4. Discussion
The D-2 strain, which was isolated from rotten silage samples, was revealed to be
Bacillus velezensis via morphological, physiological, biochemical, and molecular characterization.
Bacillus produces many metabolites with antibiotic activity during growth and multiplication [
31]. Other studies showed that
B. velezensis has a good antagonistic effect against pathogenic and rot-causing microorganisms, such as
E. coli,
S. aureus, and
F. graminearum, and has the potential to promote animal growth and disease resistance [
32,
33]. These previous findings agree with the results of this study. In addition, the D-2 strain screened in our study shows some inhibitory effects against
A. niger,
S. cerevisiae, and
S.
enteritidis, but not against
L. reuteri,
E. faecium, and
L. casei, providing a foundation for the use of this strain during ensiling.
During silage fermentation, the silage central temperature can reach up to 70 °C [
34], and the pH of silage systems can reduce to four during the rapid fermentation stage [
3]. In this study, D-2 was screened under anoxic conditions, and it can survive in an environment with a pH ranging from two to ten and tolerate 70 °C. D-2 can tolerate different pH values, temperatures, and lactic acid contents, has good antibacterial spectrum characteristics, and is sensitive to the eight tested antibiotics. It also provides a favorable environment for the proliferation of LABs by inhibiting the growth of pathogenic and rot-causing microorganisms consuming oxygen and improving the fermentation quality. D-2 is expected to be successfully applied to corn silage fermentation. When silage is exposed to air, oxygen triggers the activity of microorganisms such as yeasts and molds. In addition, the loss of volatile fatty acids such as acetic and butyric acids in silage results in a decrease in organic acid concentration, diminishing the inhibitory effect of organic acids on yeasts and molds. With prolonged exposure, yeasts, molds, and other spoilage bacteria gradually become the dominant microbes [
6,
7]. D-2 can inhibit yeasts and molds, but not LAB. Thus, the D-2 group has a significantly lower number of yeasts and molds than the control group does.
NH
4+-N exists in silage as free ammonia (NH
3) or ammonium salt (NH
4+), and their composition ratio depends on the pH; they are present in a free state when the pH is high, or conversely, in an ammonium salt form. In high-quality silage, NH
4+-N is present in the form of ammonia salt, but when the silage is seriously decayed, it has a pungent ammonia smell. NH
4+-N in silage is produced by the decomposition of nitrogen-containing organic substances by plant enzymes and aerobic bacteria [
35]. Therefore, the content of NH
4+-N can be used as an indicator of the degree of protein decomposition. The NH
4+-N/TN ratio reflects the degree of protein and amino acid decomposition in silage, and a large ratio indicates increased protein decomposition and the poor quality of silage. In this study, D-2 inhibited the proliferation of spoilage microorganisms, resulting in a lower NH
4+-N content and NH
4+-N/TN ratio in the D-2 group compared to the control group. This finding shows that D-2 has a protective effect on the aerobic stability of silage and can delay proteolysis via aerobic exposure and extend the shelf-life of silage under aerobic exposure. Water activity (WA) is an important indicator of bacterial activity [
36]. In this study, the effect of WA is excluded as a plastic film covered the samples, which were placed in an environment with a constant temperature and humidity. Given the decomposition microorganisms, the DM of silage is reduced, which increases the relative proportion of NDF and ADF in the treatment group, but no difference is observed among these groups (
p > 0.05). The main feature of silage spoilage is protein degradation, with a minimal effect on the NDF and ADF.
The low pH of silage can inhibit the activity of undesirable microbes and stop the loss of organic matter in silage fermentation [
37]. In this study, compared with the control group, the D-2 group had a lower pH in the whole-plant corn silage, and D-2 can also inhibit the activity of undesirable microbes in silage, so it is speculated that the D-2 group loses less organic matter and more DM. In the rumen, a small amount of hydrogen (1 μmol·L
−1) is produced during metabolite conversion, and both propionic acid and methane production need to consume hydrogen, causing competition between the two [
38]. The content of propionic acid in the D-2 group was higher than that in the control group. It is speculated that after fermentation with D-2, the propionic acid production pathway was enhanced, more hydrogen was utilized by this pathway, the concentration of hydrogen in the rumen was reduced, and methane production was inhibited [
39].
D-2 demonstrated many application advantages. However, it was conducted under laboratory conditions, which minimized external interference to the greatest extent possible. In actual production, the natural temperature and larger silos may influence the results. In addition, climatic variations, the chemical composition of plants, and bacterial flora can affect the results of inoculants. Therefore, to effectively apply these findings of D-2 in practical production settings, further verification is required through repeated experiments conducted for two consecutive years or in two different locations to improve the reliability of the data obtained.